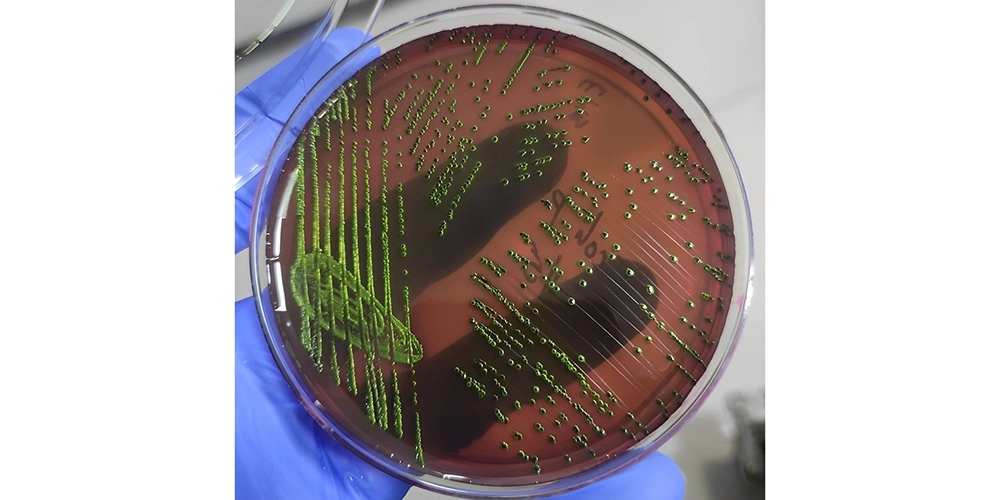
محیط کشت EMB

مشخصات محصول:
محیط کشت EMB آگار: راهنمای کامل برای جداسازی و شناسایی باکتریهای گرم منفی رودهای
محیط کشت EMB آگار (Eosin Methylene Blue Agar) یک محیط کشت انتخابی و افتراقی است که به طور گسترده در میکروبیولوژی برای جداسازی و شناسایی باکتریهای گرم منفی رودهای، به ویژه اعضای خانواده انتروباکتریاسه، استفاده میشود. این محیط کشت قادر است بین باکتریهای تخمیر کننده لاکتوز و غیر تخمیر کننده لاکتوز تمایز قائل شود و به این ترتیب به شناسایی سریع و دقیق عوامل بیماریزای رودهای کمک میکند.
ترکیب و عملکرد محیط کشت EMB آگار
-
پپتون: منبع نیتروژن، ویتامینها و مواد معدنی مورد نیاز برای رشد باکتریها را فراهم میکند.
-
لاکتوز و ساکارز: به عنوان منبع کربن و انرژی برای باکتریهای تخمیر کننده عمل میکنند.
-
فسفات دیپتاسیم: pH محیط را تنظیم میکند.
-
ائوزین Y و متیلن بلو: این رنگها نقش انتخابی و افتراقی دارند. متیلن بلو از رشد بسیاری از باکتریهای گرم مثبت جلوگیری میکند و ائوزین Y به تغییرات pH حساس است و در محیطهای اسیدی رنگ تیره ایجاد میکند.
مکانیسم عمل
-
انتخابی: رنگهای ائوزین و متیلن بلو از رشد بسیاری از باکتریهای گرم مثبت جلوگیری میکنند و محیط را برای رشد باکتریهای گرم منفی رودهای انتخابی میسازند.
-
افتراقی: باکتریهایی که لاکتوز را تخمیر میکنند، اسید تولید میکنند که باعث کاهش pH محیط میشود. در نتیجه، رنگ ائوزین Y در اطراف کلنیها تیره شده و یک درخشش فلزی ایجاد میکند. باکتریهایی که لاکتوز را تخمیر نمیکنند، کلنیهای بیرنگ یا صورتی کم رنگ ایجاد میکنند.
محیط کشت ائوزین متیلن بلو آگار شارلو
محیط کشت emb agar
کاربردهای محیط کشت EMB آگار
-
جداسازی و شناسایی کلیفرمها: این محیط کشت به طور گسترده برای جداسازی و شناسایی کلیفرمها (باکتریهای گرم منفی رودهای) از نمونههای آب، غذا و مدفوع استفاده میشود.
-
تشخیص سالمونلا و شیگلا: باکتریهای جنس سالمونلا و شیگلا معمولاً لاکتوز را تخمیر نمیکنند و در این محیط کلنیهای بیرنگ یا صورتی کم رنگ ایجاد میکنند.
-
تعیین کیفیت میکروبی مواد غذایی: از این محیط کشت برای ارزیابی کیفیت میکروبی مواد غذایی، به ویژه محصولات لبنی، استفاده میشود.
تفسیر نتایج
-
کلنیهای آبی تیره با درخشش فلزی: نشاندهنده تخمیر لاکتوز توسط باکتریهای رودهای است.
-
کلنیهای صورتی کم رنگ یا بیرنگ: نشاندهنده عدم تخمیر لاکتوز است و ممکن است مربوط به سالمونلا، شیگلا یا سایر باکتریهای غیر تخمیر کننده لاکتوز باشد.
-
کلنیهای بیرنگ با مرکز سیاه: ممکن است مربوط به تخمیر ساکارز باشد.
مزایای استفاده از محیط کشت EMB آگار
-
سادگی و سرعت: تهیه و استفاده از این محیط کشت بسیار ساده است و نتایج به سرعت قابل تفسیر هستند.
-
گستردگی کاربرد: این محیط کشت در صنایع غذایی، آزمایشگاههای بالینی و محیط زیست کاربرد دارد.
-
هزینه مناسب: نسبت به سایر محیطهای کشت تخصصی، هزینه کمتری دارد.
محدودیتها
-
عدم اختصاصیت کامل: برخی از باکتریهای گرم منفی غیر رودهای نیز ممکن است در این محیط رشد کنند.
-
تداخل با برخی رنگها: برخی از رنگها و مواد شیمیایی ممکن است با عملکرد رنگهای ائوزین و متیلن بلو تداخل داشته باشند.
در نتیجه، محیط کشت EMB آگار یک ابزار ارزشمند برای میکروبیولوژیستها است که به آنها امکان میدهد به سرعت و دقت باکتریهای گرم منفی رودهای را شناسایی و تفکیک کنند.
توجه: برای تفسیر دقیق نتایج و شناسایی دقیق گونههای باکتریایی، انجام تستهای تکمیلی مانند تستهای بیوشیمیایی و تستهای مولکولی ضروری است.
Scharlau یک برند معتبر اسپانیایی است که در زمینه تولید مواد شیمیایی آزمایشگاهی، محیطهای کشت، حلالهای کروماتوگرافی، و معرفهای تحلیلی فعالیت میکند. این شرکت در شهر بارسلونا مستقر بوده و با بیش از 40 سال سابقه، یکی از تأمینکنندگان اصلی در حوزه علوم زیستی، دارویی، محیط زیست و صنایع غذایی است.
محصولات شارلو به دلیل خلوص بالا، بستهبندی ایمن، تطابق با استانداردهای بینالمللی (مانند ISO و ACS)، در بسیاری از آزمایشگاههای تحقیقاتی و صنعتی جهان مورد استفاده قرار میگیرند. این برند همچنین دارای مجموعه متنوعی از مواد شیمیایی با گریدهای مختلف از جمله تحلیلی، دارویی، و صنعتی است.